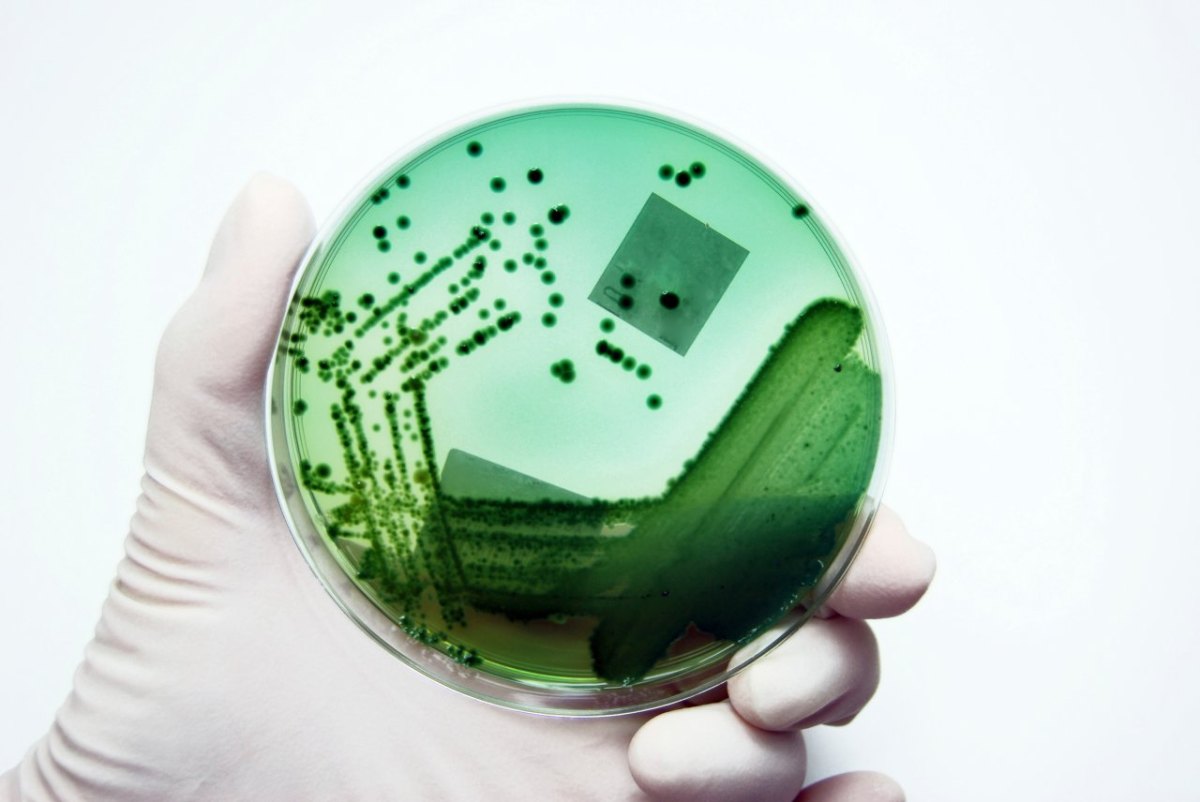
Petrischale.jpg

Düsseldorf/Duisburg.
Es ist eine lebensbedrohende Grauzone mitten in NRW. Mindestens vier Keimausbrüche in anderthalb Jahren, zwei in Düsseldorf, zwei in Duisburg, zwei offiziell gemeldet, die beiden anderen von dieser Redaktion entdeckt, zwei Tote, zwölf schwer Erkrankte und die Frage: Warum verbergen Kommunen und Kliniken gravierende Infektionswellen mit tödlichen Bakterien vor dem Bürger?In Duisburg sterben Menschen mit einem Krankheitserreger, den es offiziell nicht gibt in der Stadt. An Vancomycin-resistenten Enterokokken, kurz: VRE. Das sind Bakterienstämme, gegen die maximal zwei Antibiotika wirken. Nach Recherchen dieser Redaktion hat es zwei VRE-Ausbrüche in Duisburg gegeben, je einen 2012 und 2013. Zwei Menschen sind dabei gestorben, mindestens sieben schwer erkrankt. In den Akten der zuständigen Landesbehörde tauchen die Fälle nicht auf. Die Stadt hat sie nicht nach oben gemeldet.
Das Gesundheitsamt steht wieder im Brennpunkt
Wieder Duisburg, wieder das Helios-Klinikum, wieder die Klinik St. Johannes, in der es seit Jahren die meisten MRSA-Fälle in der Stadt gibt. Und: Wie bei dem Duisburger Datenleck, durch das zahlreiche MRSA-Erkrankungen unter den Tisch fielen, steht wieder das Gesundheitsamt im Brennpunkt. Zu VRE teilt die Behörde schriftlich mit, „dass es in Duisburg bislang keine (dokumentierten) Erkrankungsfälle gegeben hat“. Doch es hat solche Fälle gegeben. Sie sind auch dokumentiert. Dieser Zeitung liegen die Unterlagen dazu vor.
Januar 2012: Auf der operativen Intensivstation der Helios-Klinik St. Johannes in Hamborn bricht VRE aus. Ein Patient hat plötzlich Bakterien im Blut. Sie vergiften seinen Körper. Die mikrobiologische Untersuchung belegt: Es sind Vancomycin-resistente Enterokokken. Kurz darauf sind fünf Patienten auf der Intensivstation von dem Keim befallen. Vier erleiden eine Sepsis, eine Blutvergiftung. Einer stirbt nach Leberversagen.
Am 5. März 2012 meldet das Helios-Klinikum St. Johannes den VRE-Ausbruch an das Duisburger Gesundheitsamt – als Erkrankungshäufung mit „epidemiologischem Zusammenhang“. Und als einen Fall „mit Gefährdung für die Allgemeinheit“. Am Ende sind drei Patienten mit VRE infiziert, einer mit dem Keim besiedelt, einer tot.
Das Duisburger Gesundheitsamt kennt diese Bilanz des VRE-Ausbruchs. Das Landeszentrum Gesundheit (LZG) weiß nichts von den Fällen. Dabei hätten sie laut LZG dorthin übermittelt werden müssen. Seit Ende Juli 2011 herrsche eine Meldepflicht – zwar nicht für einzelne VRE-Fälle, aber für das gehäufte Auftreten von VRE-Erkrankungen in Kliniken. Sobald zwei Personen zugleich mit dem Bakterium infiziert seien, müsse der Fall dem Land gemeldet werden. Das schreibe das Infektionsschutzgesetz vor.
Es bleibt nicht bei dem einen VRE-Ausbruch in Duisburg. Das Gesundheitsamt kennt einen weiteren. Auch der ereignet sich in St. Johannes, erneut auf der Intensivstation. Helios hat den Fall am 21. März 2013 der Stadt gemeldet. Das entsprechende Dokument liegt dieser Zeitung vor. Diesmal sind vier Patienten von den Keimen befallen. Wieder erfolgt keine Meldung ans Land. Gesundheitsamt und LZG hätten den Fall „nach eingehender Prüfung nicht als Ausbruch gewertet“, sagt Helios. Die Stadt spricht von einer „nicht-meldepflichtigen VRE-Besiedelung einer Wunde“. Sie bestätigt: Die VRE-besiedelte Patientin, eine 77-jährige Frau, ist tot – „an einer Sepsis verstorben“. Das Bakterium war in ihrem Blut. Es gebe aber „keinen Beweis dafür, dass ein VRE-Keim ursächlich für die Sepsis oder den Tod gewesen wäre“, sagt die Stadt. Die Frau sei „an verschiedenen Grunderkrankungen gestorben“, sagt Helios.
Der Patient, der die anderen mit VRE angesteckt hat, ist bis heute unbekannt. Helios bestätigt das. Es sei „uns nicht möglich, einen Indexpatienten zu ermitteln“. Ein Indexpatient, das ist der Ausgangspunkt eines Krankheitsausbruches: das erste Glied der Übertragungskette.
Zwei VRE-Ausbrüche in Düsseldorf, kurz hintereinander
Jetzt hat Düsseldorf Probleme mit dem lebensbedrohenden Keim. Zwei VRE-Ausbrüche in der Landeshauptstadt wurden dem LZG gemeldet, kurz hintereinander: im zweiten und dritten Quartal dieses Jahres. Die Bakterien verseuchten eine internistische Station und eine chirurgische Intensivstation. Die Stadt sagt, die Ausbruchszonen seien in unterschiedlichen Gebäuden untergebracht. Insgesamt sechs VRE-Fälle wurden gemeldet, fünf Patienten sind erkrankt, eine Person ist mit dem Keim besiedelt.
Die Stadt sagt nicht, in welchem Düsseldorfer Krankenhaus die gefährlichen Infektionen ausgebrochen sind. Begründung: Bei Nennung der Klinik werde „ein Betriebs- oder Geschäftsgeheimnis offenbart“ – und dadurch könne dem betroffenen Haus „ein wirtschaftlicher Schaden entstehen“.
Sie haben auch Erfahrungen Keimen und/oder mangelnder Hygiene in Krankenhäusern in NRW? Bitte schildern Sie uns Ihre Erlebnisse per Mail. Sie können uns auch anynom kontaktieren: